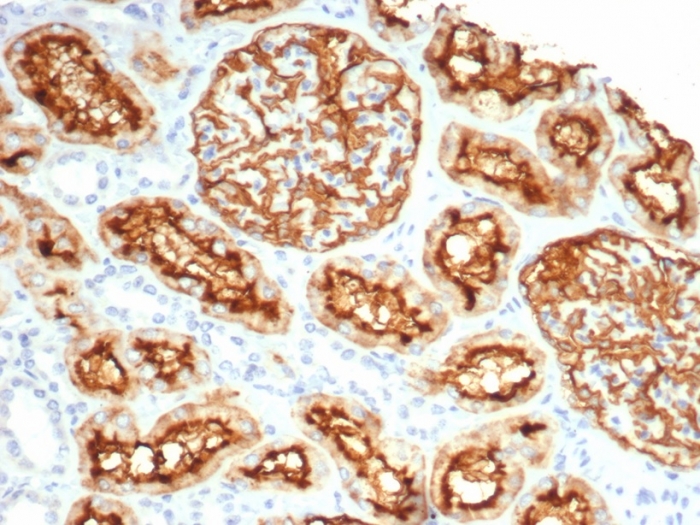

Formalin-fixed, paraffin-embedded human kidney stained with CD10 Recombinant Rabbit Monoclonal Antibody (MME/6696R). HIER: Tris/EDTA, pH9.0, 45min. 2 °: HRP-polymer, 30min. DAB, 5min.

Formalin-fixed, paraffin-embedded human prostate stained with CD10 Recombinant Rabbit Monoclonal Antibody (MME/6696R). HIER: Tris/EDTA, pH9.0, 45min. 2 °: HRP-polymer, 30min. DAB, 5min.

SDS-PAGE Analysis of Purified CD10 Recombinant Rabbit Monoclonal Antibody (MME/6696R). Confirmation of Purity and Integrity of Antibody.
Recognizes a 100kDa glycoprotein, identified as CD10, also known as Common Acute Lymphocytic Leukemia Antigen (CALLA). It is a cell surface enzyme with neutral metalloendopeptidase activity, which inactivates a variety of biologically active peptides. CD10 is expressed on the cells of lymphoblastic, Burkitt s, and follicular germinal center lymphomas, and on cells from patients with chronic myelocytic leukemia (CML). It is also expressed on the surface of normal early lymphoid progenitor cells, immature B cells within adult bone marrow and germinal center B cells within lymphoid tissue. CD10 is also present on breast myoepithelial cells, bile canaliculi, fibroblasts, with especially high expression on the brush border of kidney and gut epithelial cells.
There are no reviews yet.